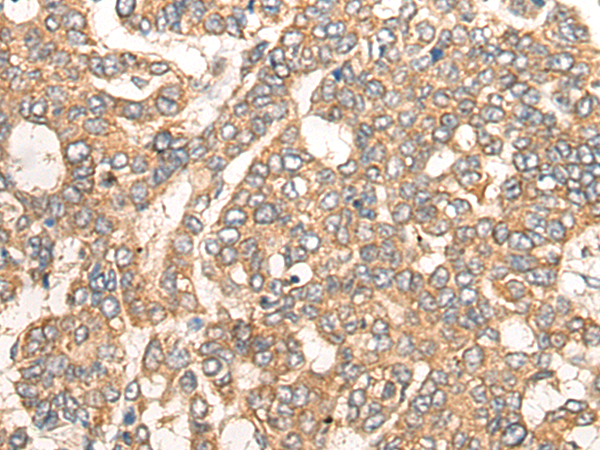

中文名稱:兔抗CCL5多克隆抗體
英文名稱: Anti-CCL5 rabbit polyclonal antibody
別 名: C-C motif chemokine ligand 5 SISd; eoCP; SCYA5; RANTES; TCP228; D17S136E; SIS-delta
儲 存: 冷凍(-20℃)
抗 原: CCL5
宿 主: Rabbit
相關類別: 一抗
反應種屬: Human, Mouse, Rat
標 記 物: Unconjugate
克隆類型: rabbit polyclonal
技術規(guī)格
|
Background: |
This gene is one of several chemokine genes clustered on the q-arm of chromosome 17. Chemokines form a superfamily of secreted proteins involved in immunoregulatory and inflammatory processes. The superfamily is divided into four subfamilies based on the arrangement of the N-terminal cysteine residues of the mature peptide. This chemokine, a member of the CC subfamily, functions as a chemoattractant for blood monocytes, memory T helper cells and eosinophils. It causes the release of histamine from basophils and activates eosinophils. This cytokine is one of the major HIV-suppressive factors produced by CD8+ cells. It functions as one of the natural ligands for the chemokine receptor chemokine (C-C motif) receptor 5 (CCR5), and it suppresses in vitro replication of the R5 strains of HIV-1, which use CCR5 as a coreceptor. Alternative splicing results in multiple transcript variants that encode different isoforms. |
|
Applications: |
ELISA, IHC |
|
Name of antibody: |
CCL5 |
|
Immunogen: |
Synthetic peptide of human CCL5 |
|
Full name: |
C-C motif chemokine ligand 5 |
|
Synonyms: |
SISd; eoCP; SCYA5; RANTES; TCP228; D17S136E; SIS-delta |
|
SwissProt: |
P13501 |
|
ELISA Recommended dilution: |
5000-10000 |
|
IHC positive control: |
Human liver cancer; |
|
IHC Recommend dilution: |
25-100 |
購物車
購物車 幫助
幫助
 021-54845833/15800441009
021-54845833/15800441009
